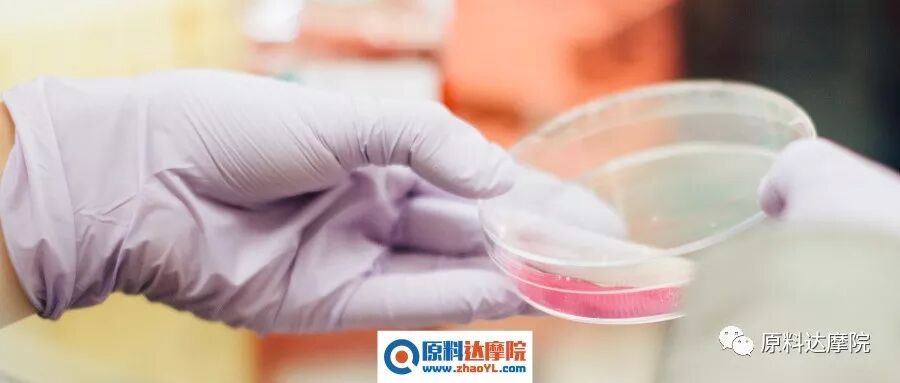

作者 | 肖进新(北京氟乐邦表面活性剂技术研究所,北京100096)
上篇回顾
中篇继续
05
合成
5.1
基本合成路线
在AAS中,疏水基团可以连接在胺或羧酸部位,或通过氨基酸的侧链进行连接。以此为基础,有4种基本的合成路线可供选择,如图7所示。
路径1
通过酯化反应生成两亲性酯胺(ester amine),在这种情况下,表面活性剂的合成通常是在脱水剂和酸性催化剂存在的情况下,通过回流脂肪醇和氨基酸来实现的。在某些反应中,硫酸同时起着催化剂和脱水剂的作用。
路径2
活化的氨基酸与烷基胺反应生成酰胺键,从而合成出两亲性酰胺基胺(amidoamine)。
路径3
通过氨基酸的胺基与脂肪酸反应合成酰胺基酸(amido acid)。
路径4
通过胺基与卤代烷的反应,合成了长链烷基氨基酸。
5.2
合成和生产方面的进展
👉 5.2.1 单链氨基酸/肽表面活性剂的合成
通过胺基或羟基与脂肪酸的酶催化酰化反应,可以合成N-酰基或O-酰基氨基酸或肽。最早关于无溶剂脂肪酶催化法合成氨基酸酰胺或甲酯衍生物的报道使用的是南极假丝酵母(Candida antarctica),根据目标氨基酸不同,产率在25%~90%。在某些反应中,甲基乙基甲酮也被用作溶剂。Vonderhagen等也描述了脂肪酶和蛋白酶催化的氨基酸、蛋白水解物和/或其衍生物的N-酰化反应,使用水和有机溶剂的混合物(如二甲基甲酰胺/水)和甲基丁甲酮。
在早期,酶催化合成 AAS的主要问题是产率太低。根据Valivety等的报道,即使使用不同的脂肪酶并在70℃下孵化很多天之后,N-十四酰氨基酸衍生物的产率也仅有2%~10%。Montet等在利用脂肪酸和植物油合成N-酰基赖氨酸的过程中,也遇到了有关氨基酸产率低的问题。根据他们的报道,在无溶剂条件和使用有机溶剂的情况下,该产物的最高产率为19%。Valivety等在合成N-Cbz-L-赖氨酸或N-Cbz-赖氨酸甲酯衍生物时也遇到同样问题。
在这项研究中,他们声称,在融化无溶剂环境下使用N-保护的丝氨酸作为底物以及Novozyme 435作为催化剂,3-O-十四酰-L-丝氨酸的产率则为80%。Nagao和Kito研究了使用脂肪酶时L-丝氨酸、L-高丝氨酸、L-苏氨酸和L-酪氨酸(LET)的O-酰化反应的结果(脂肪酶是通过Candida cylindracea和Rhizopus delemar在水缓冲介质中得到的),并报道了L-高丝氨酸和L-丝氨酸的酰化的产率在某种程度上很低,而L-苏氨酸和LET则没有发生酰化反应。
许多研究人员都支持使用廉价易得的底物合成有成本效益的AAS。Soo等声称,基于棕榈油的表面活性剂的制备中,使用固定化的脂酶(lipoenzyme)效果最好。他们指出,尽管反应耗时很长(6天),但产物的产率会更好。Gerova等研究了基于蛋氨酸、脯氨酸、亮氨酸、苏氨酸、苯丙氨酸和苯基甘氨酸的手性N-棕榈酰AAS的旋光的/外消旋的混合物的合成及表面活性。Pang和Chu描述了基于氨基酸的单体和基于二元羧酸的单体在溶液中的共缩聚反应,合成了一系列功能性的、可生物降解的基于氨基酸的聚酰胺酯。
Cantacuzene和Guerreiro报道了Boc-Ala-OH和Boc-Asp-OH的羧酸基团与长链脂肪醇和二醇所发生的酯化反应,其中二氯甲烷作溶剂、琼脂糖4B (Sepharose 4B)作催化剂。在该研究中,Boc-Ala-OH与高达16个碳原子的脂肪醇反应所得产率很好(51%),而对于Boc-Asp-OH则是6和12个碳原子更佳,相应产率为63% [64] 。Clapes等报道了在木瓜蛋白酶(来自于番木瓜乳汁)存在下,N-精氨酸烷基酰胺衍生物(纯度99.9%)的产率为58%~76%,其合成是通过Cbz-Arg-OMe与多种长链烷基胺形成酰胺键或与脂肪醇形成酯键,这里木瓜蛋白酶作为催化剂。
👉 5.2.2 gemini型氨基酸/肽表面活性剂的合成
基于氨基酸的gemini表面活性剂由两个直链AAS分子组成,彼此通过一个间隔基头对头地连结在一起。对于化学酶法合成gemini型的基于氨基酸的表面活性剂有2种可能的方案(图8和9)。在图8中,2个氨基酸衍生物与作为间隔基的化合物发生反应,然后引入2个疏水基。在图9中,2个直链结构直接通过一个双官能团的间隔基连接在一起。
最早是Valivety等率先开发gemini脂氨基酸(lipoamino acid)的酶催化合成。Yoshimura等研究了一种基于胱氨酸和n-烷基溴的基于氨基酸的gemini表面活性剂的合成、吸附和聚集。将所合成的表面活性剂与相应的单体表面活性剂进行了比较。Faustino等描述了以L-胱氨酸、D-胱氨酸、DL-胱氨酸、L-半胱氨酸、L-蛋氨酸和L-磺基丙氨酸为基础的阴离子型基于尿素的单体AAS及其对的gemini的合成,并用电导、平衡表面张力和稳态荧光的手段对其进行表征。研究表明,通过比较单体和gemini,gemini的cmc值较低。
👉 5.2.3 甘油脂氨基酸/肽表面活性剂的合成
甘油脂氨基酸/肽表面活性剂(glycerolipid amino acid/peptide surfactants)是一类新型脂氨基酸,它们是甘油单酯(或二酯)和磷脂的结构类似物,由于其结构为1或2个脂肪链与1个氨基酸通过酯键与甘油骨架连结在一起。这类表面活性剂的合成首先是在升高温度以及在酸性催化剂(如BF 3)存在的情况下先制备氨基酸的甘油酯。酶催化合成(利用水解酶、蛋白酶和脂肪酶作催化剂)也是很好的选择(图10)。利用木瓜蛋白酶,采用酶催化合成双月桂酰化的精氨酸甘油酯结合物已有报道。由乙酰基精氨酸合成二酰基甘油脂结合物并评价其物理化学性质也有了报道。
👉 5.2.4 bola型氨基酸/肽表面活性剂的合成
基于氨基酸的bola型两亲物含有2个氨基酸,这2个氨基酸与同1个疏水链相连接。 Franceschi等描述了具有2个氨基酸(D-或L-丙氨酸或L-组氨酸)和1个不同长度烷基链的bola型两亲物的合成,并研究了其表面活性。他们讨论了新型bola型两亲物的合成和聚集,该bola型两亲物具有氨基酸部分(使用不常见的β-氨基酸或一种醇)以及C12 -C20的间隔基。所用的不常见的β-氨基酸可以是氨基糖酸(sugar aminoacid)、一种叠氮基胸腺激素(azidothymin)(AZT)衍生的氨基酸、一种降冰片烯氨基酸(norbornene amino acid) 和一种由AZT衍生的氨基醇(图11)。Polidori等描述了由三羟甲基氨基甲烷(Tris)衍生的对称性的bola型两亲物的合成(图11)。
06
物理化学性质
众所周知,基于氨基酸的表面活性剂(AAS)性质多样、用途广泛,在很多应用中具有很好的适用性,比如良好的增溶性、良好的乳化性能、高效率、高表活性能以及良好的抗硬水能力(钙离子耐受性)。
基于氨基酸的表面活性剂的性质(如表面张力、cmc、相行为和Krafft温度),经过大量研究,得出以下结论——AAS的表面活性优于其对应的传统表面活性剂的表面活性。
6.1
临界胶束浓度(cmc)
临界胶束浓度是表面活性剂的重要参数之一,支配着很多表面活性性质,如增溶性、细胞溶解作用及其与生物膜的相互作用等等。一般来说,增加碳氢尾巴的链长(增加疏水性)会导致表面活性剂溶液的cmc值减小,从而增加其表面活性。与传统的表面活性剂相比,基于氨基酸的表面活性剂通常具有较低的cmc值。
通过头基和疏水尾巴的不同组合(单阳离子酰胺、双阳离子酰胺、双阳离子酰胺基酯),Infante等合成了3种基于精氨酸的AAS,并研究其cmc和
γcmc(cmc处的表面张力),结果表明随着疏水尾巴长度的增加,cmc和γcmc值减小。在另一项研究中,Singare和Mhatre发现,N-α-酰基精氨酸表面活性剂的cmc随着疏水尾巴碳原子数的增多而减小(表1)。
Yoshimura等研究了半胱氨酸衍生的基于氨基酸的gemini表面活性剂的cmc,结果表明疏水链中碳链长度从10增加到12时,其cmc下降。进一步将碳链长度增加到14,则导致cmc增大,这证实了长链gemini表面活性剂具有较低的聚集倾向。
Faustino等报道了基于胱氨酸的阴离子型gemini表面活性剂的水溶液中混合胶束的形成。同时将gemini表面活性剂与对应的传统的单体表面活性剂(C 8 Cys)进行了比较。据报道,脂质-表面活性剂混合物的cmc值比纯表面活性剂的cmc值要低。gemini表面活性剂和1,2-二庚酰-sn-甘油基-3-磷酸胆碱(一种水溶性的、能形成胶束的磷脂)其cmc为毫摩尔级别。
Shrestha和Aramaki研究了无外加盐时,混合型基于氨基酸的阴离子-非离子表面活性剂的水溶液中粘弹性蠕虫状胶束的形成。在这项研究中,发现N-十二烷基谷氨酸具有更高的Krafft温度;然而,当用碱性氨基酸L-赖氨酸中和后,它生成了胶束,并且溶液在25 ℃开始表现得像牛顿流体。
6.2
良好的水溶性
AAS良好的水溶性是由于存在额外的CO-NH键。与相应的传统表面活性剂相比,这使得AAS更容易生物降解且环境友好。N-酰基-L-谷氨酸由于具有2个羧基,其水溶性甚至更佳。Cn(CA) 2 的水溶性也很好,因为1个分子中有2个离子性的精氨酸基团,因而在细胞界面上的吸附和扩散更为有效,甚至在较低浓度下就能有效抑菌。
6.3
Krafft 温度和 Krafft 点
Krafft温度可理解成表面活性剂特殊的溶解性行为,这些表面活性剂的溶解度在高于某一特定温度后急剧增大。离子表面活性剂具有生成固体水合物的倾向,其能够从水中沉淀出来。在某一特定温度(即所谓的Krafft温度),通常会被观察到表面活性剂的溶解度剧烈而不连续的增加。离子表面活性剂的Krafft点就是其在cmc时的Krafft温度。
该溶解性特征通常见于离子表面活性剂,可这样解释:在低于Krafft温度时表面活性剂游离单体的溶解度有限,直到达到Krafft点,由于胶束的形成,其溶解度逐步增加。为保证完全溶解,有必要在高于Krafft点的情况下制备表面活性剂配方。
AAS的Krafft温度已有很多研究,并与传统合成表面活性剂进行了比较。Shrestha和Aramaki研究了基于精氨酸的AAS的Krafft温度,发现其临界胶束浓度表现为在高于2~5×10 -6 mol·L -1 时具有形成预胶束这种聚集行为、随后是正常胶束的形成(在3~6×10 -4 mol·L -1 )。Ohta等合成了6种不同类型的N-十六酰基AAS并讨论了其Krafft温度与氨基酸残基之间的关系。
在实验中,发现N-十六酰基AAS的Krafft温度随着氨基酸残基(苯丙氨酸是个例外)尺寸的减小而升高,而溶解热(吸热)则随着氨基酸残基尺寸的减小而增大(甘氨酸和苯丙氨酸例外)。由此得出结论,在丙氨酸体系和苯丙氨酸体系中,均为在固体形态的N-十六酰基AAS盐中D-L相互作用要强于L-L相互作用。
Brito等利用差示扫描微量热法测定了3个系列的基于氨基酸的新型表面活性剂的Krafft温度,发现将三氟醋酸根离子变为碘离子会导致Krafft温度明显升高(约为6 ℃),从47 ℃升高至53 ℃。顺式双键的存在以及存在于长链Ser-衍生物中的不饱和性使得Krafft温度显著降低。N-十二烷基谷氨酸被报道具有较高的Krafft温度。然而,与碱性氨基酸L-赖氨酸中和后导致溶液中形成胶束,在25℃行为类似牛顿流体。
6.4
表面张力
表面活性剂的表面张力与疏水部分的链长有关。Zhang等用Wilhelmy板法测定了椰油酰甘氨酸钠的表面张力(25±0.2)℃,测定cmc处的表面张力值为33 mN·m -1 ,cmc为0.21 mmol·L -1。Yoshimura等测定了2C n Cys型基于氨基酸的表面活性剂的表面张力 [83] 。结果发现cmc处的表面张力随着链长的增加而减小(直到n = 8),而对于n = 12或更长链长的表面活性剂,该趋势则正相反。
CaC1 2 对二羧基的氨基酸型表面活性剂的表面张力的影响亦有研究 [84,85] 。在这些研究中,将 CaC1 2 添加到3种二羧基的氨基酸型表面活性剂(C12 MalNa 2、C12 AspNa 2、C12 GluNa 2)的水溶液中。将cmc之后的平台值进行比较,发现表面张力在非常低的 CaC1 2 浓度下就有所降低。这是由于钙离子对表面活性剂在气-水界面处的排列造成的影响。N-十二烷基氨基丙二酸的盐和N-十二烷基天冬氨酸的盐的表面张力则达到10 mmol·L -1 CaC1 2 浓度时,也几乎不变。高于10 mmol·L -1,表面张力急剧增大,由于形成了表面活性剂的钙盐沉淀。对于N-十二烷基谷氨酸的二钠盐,适量加入 CaC1 2 导致表面张力显著降低,而继续增大CaC1 2 浓度则不再引起显著变化。
为测定gemini型AAS在气-水界面处的吸附动力学,利用最大泡压法测定动态表面张力。结果表明,对于最长的测试时间,2C 12 Cys动表面张力没有变化。动表面张力的下降只取决于浓度、疏水尾巴的长度以及疏水尾巴的数目。表面活性剂的浓度增大、链长以及链数目的减小使得衰减更迅速。较高浓度的C n Cys(n = 8~12)所得结果发现非常接近于通过Wilhelmy法测得的γ cmc 。
在另一项研究中,通过Wilhelmy板法测定了双月桂酰胱氨酸钠(SDLC)和二癸酰胺基胱氨酸钠(sodium didecamino cystine)的动表面张力,另外,通过滴体积法测定了其水溶液的平衡表面张力。通过其他方法也对二硫键的反应做了进一步研究。将巯基乙醇加入到0.1 mmol·L -1SDLC溶液中导致表面张力迅速上升,从34 mN·m -1 升高到53 mN·m -1 。由于NaClO可以将SDLC的二硫键氧化成磺酸基,当NaClO(5 mmol·L -1 )加入到0.1 mmol·L -1 SDLC溶液中时,观察不到聚集体。透射电子显微镜和动态光散射结果表明溶液中无聚集体形成。发现SDLC的表面张力在20 min的时间里从34 mN·m -1 增大到60 mN·m -1 。
6.5
二元表面相互作用
在生命科学领域,有很多课题组研究了阳离子型AAS(基于二酰基甘油精氨酸的表面活性剂)和磷脂的混合物在气-水界面处的振动性质,最后得出结论,这种非理想特性造成了静电相互作用的普遍性。
6.6
聚集性质
动态光散射常用于测定基于氨基酸的单体和gemini表面活性剂在浓度高于cmc时的聚集性质,可得到表观流体力学直径D H (= 2R H )。与其他表面活性剂相比,C n Cys和2Cn Cys形成的聚集体相对较大且尺度分布很宽。除2C 12 Cys之外的其他表面活性剂通常形成大约10 nm的聚集体。gemini表面活性剂的胶束尺寸显著大于其单体对应物的胶束尺寸。碳氢链长的增加也会导致胶束尺寸的增大。Ohta等描述了N-十二烷基-苯基-丙氨酰基-苯基-丙氨酸四甲铵的3种不同立体异构体的水溶液的聚集性质,结果表明,非对映异构体在水溶液中具有相同的临界聚集浓度。Iwahashi等通过圆二色谱、NMR和蒸汽压渗透测定法研究了有旋光性的N-月桂酰-L-谷氨酸、N-月桂酰-L-缬氨酸及其甲酯在不同溶剂中(如四氢呋喃、乙腈、1,4-二氧六环和1,2-二氯乙烷)手性聚集体的形成。
6.7
界面吸附
基于氨基酸的表面活性剂的界面吸附及其与传统对应物的比较也是研究方向之一。例如,研究由LET和LEP获得的芳香族氨基酸的十二烷基酯的界面吸附性质。结果表明,LET和LEP在气液界面和在水/己烷界面分别表现出更低的界面面积。
Bordes等研究了3种二羧基的氨基酸表面活性剂的溶液行为和在气-水界面处的吸附,这3种表面活性剂分别是十二烷基谷氨酸、十二烷基天冬氨酸和氨基丙二酸三者的二钠盐(两个羧基之间分别有3、2、1个碳原子)。根据该报道,二羧基的表面活性剂的cmc比单羧基的十二烷基甘氨酸盐高4~5倍。这归结于二羧基的表面活性剂通过其中的酰胺基团与邻近分子之间形成的氢键。
6.8
相行为
表面活性剂在浓度很高时观察到各向同性不连续立方相。头基很大的表面活性剂分子容易形成较小的正曲率的聚集体。Marques等研究了12Lys12/12Ser和8Lys8/16Ser体系(见图12)的相行为 ,结果表明,12Lys12/12Ser体系的胶束溶液区和囊泡溶液区之间为相分离区,而8Lys8/16Ser体系则表现为一个连续转变的过程(小胶束相区和囊泡相区之间为拉长的胶束相区)。需要指出的是,对于12Lys12/12Ser体系的囊泡区,囊泡始终是与小胶束共存的,而8Lys8/16Ser体系囊泡区则只有囊泡。
6.9
乳化能力
Kouchi等考察了N-[3-十二烷基-2-羟丙基]-L-精氨酸,L-谷氨酸盐以及其他AAS的乳化能力、界面张力、分散能力和粘度。与合成表面活性剂(其传统非离子型和两性型对应物)对比,结果表明AAS具有比传统表面活性剂更强的乳化能力。
Baczko等合成了新型的阴离子型氨基酸表面活性剂,考察其是否适用于作为手性取向核磁的溶剂(chiral oriented NMR spectroscopy solvents)。通过将氨基酸与邻磺基苯甲酸酐反应,合成一系列不同疏水尾巴(戊基~十四烷基)的磺酸盐型两亲L-Phe或L-Ala衍生物。Wu等合成了N-脂肪酰基AAS的钠盐,考察其在水包油乳液中的乳化能力,结果表明乙酸乙酯做油相时这些表面活性剂的表现比正己烷做油相时更好。
6.10
合成和生产方面的进展
抗硬水能力可理解为表面活性剂对于硬水中存在的诸如钙、镁等离子的抵抗能力,即避免沉淀变成钙皂的能力。耐硬水性较强的表面活性剂对于洗涤剂配方和个人护理产品非常有用。可以通过计算在钙离子存在下表面活性剂的溶解度和表面活性的变化来评价抗硬水能力。
另一种评价抗硬水能力的方法是计算100 g油酸钠所形成的钙皂分散在水中所需表面活性剂的百分数或克数。在硬水较高的地区,高浓度的钙、镁离子和矿物含量会给某些实际应用带来困难。通常钠离子被用作合成的阴离子表面活性剂的反离子。由于二价的钙离子与两个表面活性剂分子结合,导致表面活性剂更容易从溶液中沉淀使得洗涤性下降。
AAS的抗硬水能力的研究表明耐酸性和耐硬水性强烈受到一个额外的羧基的影响,而且随着两个羧基之间的间隔基长度的增加耐酸性和耐硬水性进一步增大。耐酸性及耐硬水性的顺序依次为C 12 甘氨酸盐 < C 12 天冬氨酸盐 < C 12 谷氨酸盐。分别比较二羧基酰胺键和二羧基氨基表面活性剂,发现后者的pH范围更宽,其表面活性随着酸的适量加入而增大。二羧基N-烷基氨基酸在钙离子存在下具有螯合效应,C 12 天冬氨酸盐形成白色凝胶。C 12 谷氨酸盐在高Ca 2+浓度下表现出高表面活性,有望用于海水淡化。
6.11
分散性
分散性(dispersability)是指表面活性剂防止表面活性剂在溶液中凝聚和沉降的能力。分散性是表面活性剂的重要性质,使其适用于洗涤剂、化妆品和药物。分散剂(dispersing agent)必须在疏水基和末端亲水基之间(或者直链疏水基当中)含有酯键、醚键、酰胺键或氨基。
通常,阴离子表面活性剂如烷醇酰胺硫酸盐以及两性离子表面活性剂如酰胺基磺基甜菜碱做为钙皂分散剂特别有效。
很多研究工作测定了AAS的分散性,其中N-月桂酰赖氨酸被发现与水的相容性很差,很难用来制作化妆品配方。在该系列中,N-酰基取代的碱性氨基酸具有超强的分散性,并被用于化妆品工业以改进配方。
· END ·
作者 | 肖进新
编辑 | 小朱同学
图源 | 网络
推荐阅读